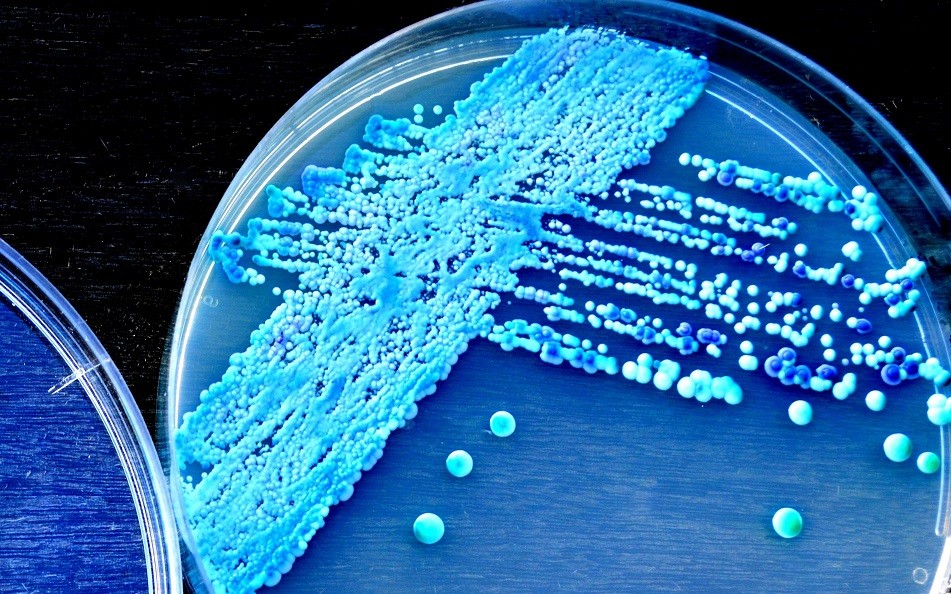

Pravda nebo lež? Kvasinková infekce je - tak jako mnoho jiných onemocnění - opředena různými mýty, takže o ní máme mnohdy mylné informace. Vaginální mykóza postihuje většinu žen a ať už jde o akutní nebo chronické problémy, jejich vznik nesouvisí s nedostatečnou hygienou. V žádném případě se za ně nemusíte stydět.
Příznaky, které jen tak nepřehlédnete
Toto onemocnění způsobuje přemnožení kvasinek, které jsou součástí poševní mikroflóry. Pokud se naruší přirozené pH pochvy, kvasinky se začnou ve velkém množit a vznikne nepříjemná mykóza. Základním příznakem je bílý (většinou hustý) výtok z pochvy a následně nepříjemné svědění a pálení. Dalšími příznaky jsou bolesti při močení nebo bolest při pohlavním styku. Těmito příznaky vám tělo dává najevo, že něco není v pořádku a je nutné problém začít řešit. Vaginální mykózu může způsobit stres, psychická zátěž, klimatické změny, hormonální změny během těhotenství, užívání antikoncepce, období menopauzy, nebo třeba léčba antibiotiky.
Jak lze nejlépe předejít kvasinkové infekci?
► Ze svého šuplíku se spodním prádlem vyhoďte syntetické spodní prádlo, tanga a také kalhotky, které jsou vám příliš těsné. Nebudete sice vypadat jako andílek od Victoria´s Secret, ale nejlepší službu vám opravdu udělá bavlněné spodní prádlo.
► Pokud opakovaně trpíte na kvasinkovou infekci, měly byste si dělat preventivní sedací koupele. Vyzkoušejte objev českých vědců - Chytrou houbu. Chytrá houba (Pythium oligandrum) si s tímto problémem totiž velmi dobře poradí. Působí jako upír na nepřátelské buňky. Zmírňuje a odstraňuje projevy spojené s kandidózou vagíny, která způsobuje svědění, pálení a výtok. Chytrá houba pomůže obnovit vaši fyziologickou mikroflóru.
► Nepoužívejte v intimních partiích deodoranty a produkty s výraznou parfemací.
► Dodržujte zdravou životosprávu a snažte se vyhýbat stresu.
► Vyhýbejte se jídlům s vysokým obsahem cukru, ta totiž podporují vznik kvasinkové infekce.
► Po plavání ve veřejných bazénech použijte sprchu.

Jaké mýty kolují o kvasinkové infekci? Co je a co není pravda?
Určitě jste slyšeli různé lži nebo polopravdy týkající se tohoto tématu. Mezi nejčastější patří tyto mýty.
1. Mýtus – Bílý jogurt má blahodárné účinky: Bílý jogurt v určité míře pomáhá, ale ne tak, jak je třeba. Určitě se nezbavíte nepříjemné mykózy tak, že si své intimní partie natřete bílým jogurtem. Použitím této potraviny příznaky pouze zmírníte, na chvilku se vám uleví, avšak svůj problém rozhodně nevyřešíte.
2. Mýtus – Každé svrbění je vaginální mykóza: Mnoho žen si myslí, že každé svědění a pálení v pochvě je způsobeno infekcí. Není to úplně pravda, protože ve skutečnosti se za tím mohou skrývat jiné problémy. Může jít o hormonální změny v těle, nebo o reakci na váš oblíbený prací prostředek.
3. Mýtus – Zvýšená produkce poševního výtoku je způsobená mykózou: Pravidelný výtok je součástí pročišťování pochvy. Není hned nutné se strachovat. Při výtocích je velmi důležité všímat si i konzistence nebo zbarvení.
4. Mýtus – Pití octové vody vás vyléčí: Domácí vynálezy nemusí být na škodu, ale určitě vám nepostačí k vyřešení problému. Jablečný ocet zředěný s vodou je prý účinným prostředkem na tlumení svědění a pálení, ale samotného zánětu vás nezbaví, takže nepříjemné pocity se opět zopakují.
Teetravel - Váš golfový svět na dlani